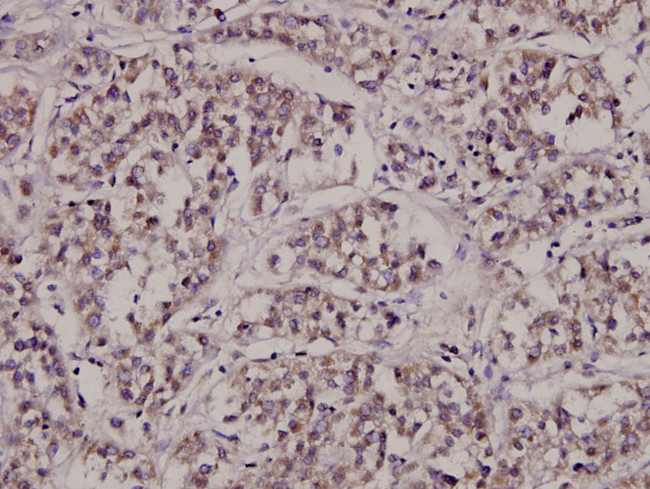
CTPS Antibody in Immunohistochemistry (Paraffin) (IHC (P))

Search
Invitrogen
CTPS Polyclonal Antibody
{{$productOrderCtrl.translations['antibody.pdp.commerceCard.promotion.promotions']}}
{{$productOrderCtrl.translations['antibody.pdp.commerceCard.promotion.viewpromo']}}
{{$productOrderCtrl.translations['antibody.pdp.commerceCard.promotion.promocode']}}: {{promo.promoCode}} {{promo.promoTitle}} {{promo.promoDescription}}. {{$productOrderCtrl.translations['antibody.pdp.commerceCard.promotion.learnmore']}}


Please note: We are reviewing Western blot images included in the antibody testing data in our catalog, including those provided by third parties. Unless expressly labeled or annotated as “raw-unedited”, Western blot images included in the antibody testing data in our catalog may have been edited, optimized or otherwise adjusted for presentation.
产品信息
PA5-36378
种属反应
宿主/亚型
分类
类型
抗原
偶联物
形式
浓度
规格
纯化类型
保存液
内含物
保存条件
运输条件
RRID
产品详细信息
This antibody detects endogenous protein at a molecular weight of 67 kDa.
Purity is >95% by SDS-PAGE.
靶标信息
There are two genes encoding members of a new family of type II integral membrane proteins. Both are ubiquitously expressed, and tissue-specific alternative mRNA initiation and splicing generate at least two major isoforms of each protein, with the smaller isoforms being truncated at the N-terminus. These proteins are called nesprin-l and -2 for nuclear _envelope _spectrin repeat, as they are characterized by the presence of multiple, clustered spectrin repeats, bipartite nuclear localization sequences and a conserved C-terminal, single transmembrane domain. Transient transfection of EGFP-fusion expression constructs demonstrated their localization to the nuclear membrane with a novel C-terminal, TM-domain-containing sequence essential for perinuclear localization. Nesprin-l is developmentally regulated in both smooth and skeletal muscle and is relocalized from the nuclear envelope to the nucleus and cytoplasm during C2Cl2 myoblast differentiation. Nesprins may function as 'dystrophins of the nucleus' to maintain nuclear organization and structura integrity.
仅用于科研。不用于诊断过程。未经明确授权不得转售。
篇参考文献 (0)
生物信息学
蛋白别名: CTP synthase 1; CTP synthetase 1; cytidine 5'-triphosphate synthase; cytidine 5'-triphosphate synthetase; cytidine 5-prime triphosphate synthetase; Protein-asparagine deamidase CTPS1; unnamed protein product; UTP--ammonia ligase 1
基因别名: CTPS; CTPS1; GATD5; GATD5A; IMD24
UniProt ID: (Mouse) P70698
Entrez Gene ID: (Human) 1503, (Mouse) 51797, (Rat) 313560